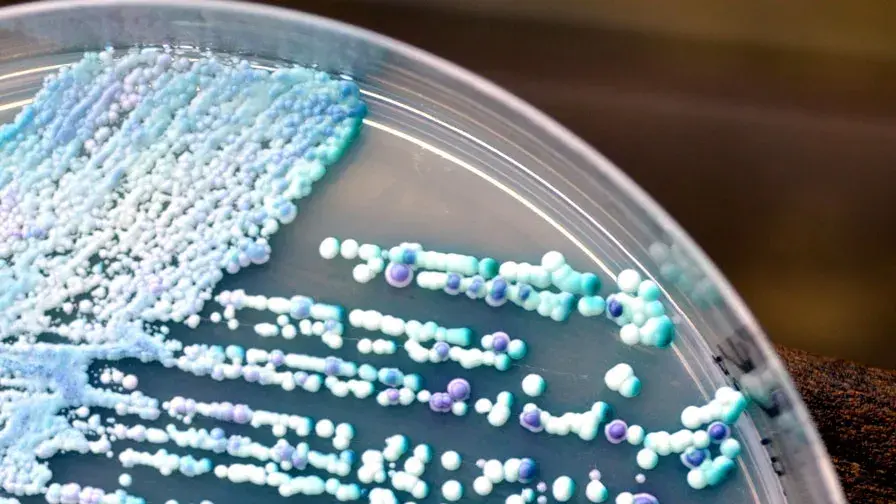

Mis à jour le 10/02/2025
Microbiote et intestin : la recherche avance
Une étude montre le rôle des champignons dans les maladies inflammatoires chroniques de l’intestin – MICI.
Le microbiote – qui désigne les bactéries, virus, champignons et levures présents à l’état normal dans nos intestins – joue un rôle dans la survenue des maladies inflammatoires chroniques de l'intestin (MICI) comme la maladie de Crohn et la rectocolite hémorragique. Ces maladies inflammatoires chroniques du système digestif évoluent par crises et phases de rémission. Il a déjà été montré qu’un déséquilibre en bactéries favorisait ces maladies, mais le microbiote fongique – la part composée des champignons et levures – n’avait été que très peu étudiée.
Une équipe de chercheurs (Equipe AVENIR-ATIP- Inserm , Inra , UPMC et AP-HP), dirigée par le Dr Harry Sokol, du service de gastro-entérologie et nutrition à l’Hôpital Saint-Antoine, Assistance Publique-Hôpitaux de Paris, AP-HP, a montré que le microbiote fongique était déséquilibré chez les patients atteints de maladies inflammatoires chroniques de l’intestin (MICI). Ces travaux ont été publiés en ligne dans la revue Gut le 4 février 2016. Cette étude est la plus importante en termes de nombre de patients analysés à ce jour. Selon le Dr Sokol, «En termes de recherche, cette étude offre des pistes pour une meilleure compréhension des relations complexes entre bactéries et champignons dans l’intestin et leur rôle dans la physiologie ainsi que dans les maladies humaines ».

